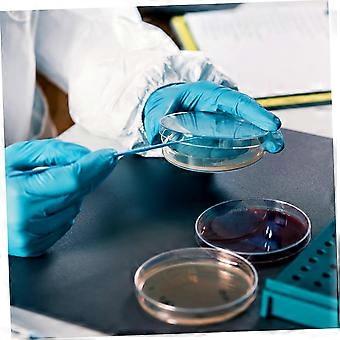
product image

Agar Plates 10 Pieces Deep Petri Dish Laboratory Supplies 90mm Sterile Agar Petri Dishes for Experiments
INGYENES kiszállítás

Agar Plates 10 Pieces Deep Petri Dish Laboratory Supplies 90mm Sterile Agar Petri Dishes for Experiments
- Márka: Unbranded
Agar Plates 10 Pieces Deep Petri Dish Laboratory Supplies 90mm Sterile Agar Petri Dishes for Experiments
- Márka: Unbranded
Megtakarítás 8 100,00 Ft (33%)
RRP
14 napos visszaküldési szabályzat
Megtakarítás 8 100,00 Ft (33%)
RRP
14 napos visszaküldési szabályzat
Fizetési módok:
Leírás
Agar Plates 10 Pieces Deep Petri Dish Laboratory Supplies 90mm Sterile Agar Petri Dishes for Experiments
- Márka: Unbranded
- Kategória: Petri csészék
- Fruugo azonosító: 383487348-825534708
- EAN: 739529190304
Kiszállítás és visszaküldés
Feladott 24 órán belül
-
STANDARD: INGYENES - közötti szállítás H 05 január 2026–Sze 21 január 2026 - INGYENES
Szállítás innen: Kína.
Minden tőlünk telhetőt megteszünk annak biztosítására, hogy rendelését hiánytalanul és előírásainknak megfelelően szállítás ki önnek. Viszont ha egy hiányos rendelést kap, vagy eltér a megrendelttől, vagy bármilyen más okból nem elégedett a rendeléssel, akkor visszaküldheti a rendelést vagy a rendelésben lévő bármely terméket, és visszatérítik a termék árának teljes összegét. Teljes visszaküldési irányelvek megtekintése.
Termékmegfelelőségi részletek
Kérjük, tekintse meg a termékre vonatkozó megfelelőségi információkat az alábbiakban.
Az alábbi információkat a terméket értékesítő független, harmadik fél kiskereskedő biztosítja.
Gyártó:
Az alábbiakban olvashatók a Fruugo platformján értékesített releváns termék gyártójának elérhetőségei.
- DazzleDaze
- Shenzhen Tuku Supply Chain Co., Ltd.
- 202-5, Jinhe Building, 8 Xinhe Street
- Maan Tang, Bantian , Longgang, Shenzhen, Guangdong
- China
- Guangdong
- CN
- 518129
- caryleroot@outlook.com
- 13428666765
Felelős személy az EU-ban:
Az alábbiakban olvashatók az Európai Unióban kijelölt felelős személy elérhetőségei. A felelős személy az az Európai Unióban székhellyel rendelkező gazdasági társaság, amely az Európai Unióban eladott releváns termékekhez kapcsolódó megfelelőségi kötelezettségekért felel.
- Synertrade FR SAS
- Synertrade FR SAS
- 9 rue du Bat d'Argent
- Lyon
- France
- Lyon
- FR
- 69001
- info@syner-sarl.cn
- (+33)774555006
- https://seller.kuajingmaihuo.com/settle/qualification-service